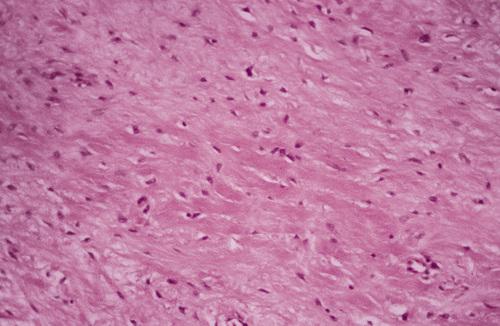

What are the two classes of odontogenic cysts?
- developmental
- inflammatory
What is the most common type of developmental odontogenic cyst?
dentigerous cyst
Clinical Features
- separation of follicle from crown of an unerupted tooth
- most often involve mandibular third molars (65%)
- most frequent in patients between 10 and 30 years
- slight male predilection, prevalence higher for whites
- asymptomatic (small) or painless bony expansion (large)
- may become infected and cause pain and swelling
Radiographic Features
- unilocular radiolucent area
- associated with the crown of an unerupted tooth
- well-defined, often corticated border (unless infected)
- root resorption of adjacent erupted teeth can occur
- radiolucent space should be at least 3 to 4 mm in diameter
Histopathologic Features
- loosely arranged fibrous connective tissue wall
- islands or cords of odontogenic epithelial rests
- two to four layers of flattened nonkeratinizing cells
- focal areas of mucous cells in epithelial lining
dentigerous cyst

Gross specimen of a cyst involving a maxillary canine tooth. The cyst has been cut open to show the cyst-to-crown relationship.
dentigerous cyst

A unilocular radiolucent cyst involving the crown of an unerupted tooth, with the crown projecting into the cystic cavity.
dentigerous cyst, central type

A unilocular radiolucent cyst along the mesial root of the unerupted molar. This cyst exhibited mucous cell prosoplasia.
dentigerous cyst, lateral type

A unilocular radiolucent cyst extending along the mesial and distal roots of the unerupted tooth.
dentigerous cyst, circumferential type

This noninflamed cyst shows a thin, nonkeratinized epithelial lining and a loosely arranged fibrous connective tissue wall.
dentigerous cyst, noninflamed

This inflamed cyst shows a thick epithelial lining with hyperplastic rete ridges and diffuse chronic inflammatory infiltrate.
dentigerous cyst, inflammed

This cyst shows scattered mucous cells within the thin epithelial nonkeratinized epithelial lining.
dentigerous cyst
What is the treatment and prognosis for dentigerous cyst?
- enucleation plus removal of the unerupted tooth
- recurrence is rare
- malignant transformation is possible, but extremely rare
Clinical Features
- soft tissue analogue of the dentigerous cyst
- soft, translucent swelling in the gingival mucosa
- overlies the crown of an unerupted tooth
- most often seen in children younger than age 10
- most
commonly associated with:
- deciduous mandibular central incisors
- permanent first molars
- deciduous maxillary incisors
Histopathologic Features
- surface oral epithelium on the superior aspect
- variable inflammatory cell infiltrate in lamina propria
- thin layer of nonkeratinizing squamous epithelium
eruption cyst

This soft gingival swelling contains considerable blood and can also be designated as an eruption hematoma.
eruption cyst

A cystic epithelial cavity can be seen below the mucosal surface with inflammatory cell infiltrate in lamina propria.
eruption cyst
What is the treatment and prognosis for eruption cyst?
- ruptures spontaneously - treatment may not be required
- if necessary simple excision permits tooth eruption

A cyst is located in the third molar area in a patient with no history of third molar extraction. The cyst was excised, and histopathologic examination revealed an odontogenic keratocyst (OKC).
primordial cyst
There is debate over reclassification of the odontogenic keratocyst (OKC) as keratocystic odontogenic tumor (KCOT). What are three reasons why are these lesions particularly significant?
Because of their (1) growth potential, (2) recurrence rate, and (3) association with nevoid basal cell carcinoma syndrome.

Clinical Features
- arises from cell rests of the dental lamina
- most often diagnosed between 10 and 40 years (60%)
- slight male predilection
- most often occurs in the mandible (60% to 80%)
- asymptomatic (small) or pain, swelling, and drainage (large)
Radiographic Features
- well-defined radiolucent area
- large lesions may appear multilocular
- smooth and often corticated margins
- growth in an anteroposterior direction
- may involve an unerupted tooth (25% to 40%)
Histopathologic Features
- thin, friable wall, difficult to enucleate in one piece
- cystic lumen may contain either:
- clear liquid similar to a transudate of serum
- cheesy material consisting of keratinaceous debris
- epithelial lining of stratified squamous epithelium
- luminal surface of flattened parakeratotic epithelial cells
- basal layer composed of a palisaded epithelial cells
odontogenic keratocyst (OKC)
What possibility should always be considered in patients who present with multiple odontogenic keratocysts (OKC)?
nevoid basal cell carcinoma (Gorlin) syndrome

This large, multilocular cyst involves most of the ascending ramus and is growing in an anteroposterior direction.
odontogenic keratocyst (OKC)

This cyst involves the crown of an unerupted premolar, which appears similar to a dentigerous cyst.
odontogenic keratocyst (OKC)

Computed tomography (CT) scan showing a large cyst involving the crown of an unerupted maxillary third molar.
odontogenic keratocyst (OKC)

The epithelial lining is 6 to 8 cells thick, with a hyperchromatic and palisaded basal cell layer. Note the corrugated parakeratotic surface.
odontogenic keratocyst (OKC)

The characteristic palisaded basal layer of this cyst has been lost in the central area due to the chronic inflammatory cell infiltrate.
odontogenic keratocyst (OKC)
What is the tratment and prognosis for odontogenic keratocyst (OKC)?
- enucleation and curettage
- often recur after treatment (5% to 62%)
- malignant tranformation is unlikely
Clinical Features
- lack distinct clinical or radiographic features
- occur predominantly in young adults
- more common in males than females (2 : 1)
- more common in mandible than maxilla (3 : 1)
Radiographic Features
- unilocular radiolucency
- size from less than 1 cm to greater than 7 cm
- appear similar to dentigerous cysts
- often involve an unerupted mandibular third molar
Histopathologic Features
- lining of orthokeratotic stratified squamous epithelium
- keratohyaline granules in the superficial epithelial layer
orthokeratinized odontogenic cyst

A small unilocular radiolucency associated with the impacted mandibular left third molar. Histopathologic examination shows a lining of orthokeratotic stratified squamous epithelium.
orthokeratinized odontogenic cyst

A large cyst involving a horizontally impacted lower third molar. Histopathologic examination shows a lining of orthokeratotic stratified squamous epithelium.
orthokeratinized odontogenic cyst

Microscopic features showing a thin epithelial lining. The basal epithelial layer does not demonstrate palisading. Keratohyaline granules are present, and a thick layer of orthokeratin is seen on the luminal surface.
orthokeratinized odontogenic cyst
What is the treatment and prognosis for orthokeratinized odontogenic cyst?
- enucleation with curettage
- recurrence is rare (2%)
- possibly slightly greater risk for malignant transformation
Nevoid basal cell carcinoma syndrome (Gorlin syndrome) is an autosomal dominant inherited condition that exhibits high penetrance and variable expressivity. What mutation causes this disease?
The syndrome is caused by mutations in patched (PTCH), a tumor suppressor gene that has been mapped to chromosome 9q22.3-q31.
Clinical Features
- enlarged head circumference
- multiple basal cell carcinomas
- epidermal cysts of the skin
- palmar/plantar pits (65% to 85%)
- mild ocular hypertelorism
- spina bifida occulta
Radiographic Features
- multiple odontogenic keratocysts (90%)
- frontal and temporal bossing
- calcified falx cerebri
- splayed, bifid, or fused ribs
Histopathologic Features
- keratocysts with a fibrous capsule having more:
- satellite cysts
- islands of epithelial proliferation
- odontogenic epithelial rests
- foci of calcification also appear to be more common
nevoid basal cell carcinoma syndrome (Gorlin syndrome)

This 11-year-old girl shows hypertelorism and mandibular swelling.
nevoid basal cell carcinoma syndrome

An ulcerating basal cell carcinoma is present on the upper face.
nevoid basal cell carcinoma syndrome

Punctate lesions representing a localized impairment of the maturation of basal epithelial cells.
nevoid basal cell carcinoma syndrome

Chest film showing presence of bifid ribs.
nevoid basal cell carcinoma syndrome

Anteroposterior skull film showing calcification of the falx cerebri.
nevoid basal cell carcinoma syndrome

Large cysts present in the right and left mandibular molar regions, together with a smaller cyst involving the right maxillary canine.
nevoid basal cell carcinoma syndrome
A diagnosis of nevoid basal cell carcinoma syndrome can be made if a patient meets two major diagnostic criteria. What are the five major criteria for nevoid basal cell carcinoma syndrome?
- five or more basal cell carcinomas (or one before 30 years old)
- odontogenic keratocyst (OKC)
- lamellar calcification of the falx cerebri
- two or more palmar or plantar pits
- first degree relative with nevoid basal cell carcinoma syndrome
A diagnosis of nevoid basal cell carcinoma syndrome can be made if a patient meets one major and two minor diagnostic criteria. What are the seven minor criteria for nevoid basal cell carcinoma syndrome?
- macrocephaly
- congenital malformations
- polydactyly
- skeletal abnormalities
- ovarian or cardiac fibromas
- medulloblastoma*
- ocular anomalies
- lymphomesenteric or pleural cysts
*has been suggested as a major criterion

Odontogenic keratocyst (OKC) showing numerous odontogenic epithelial rests in the cyst wall.
nevoid basal cell carcinoma syndrome
What is the treatment and prognosis for nevoid basal cell carcinoma syndrome?
- prognosis depends on behavior of skin tumors
- patients should take precautions to avoid sunlight
- jaw cysts are treated the same as isolated OKCs
- genetic counseling is appropriate for affected individuals

This 52-year-old man had more than 100 basal cell carcinomas removed from his face over a 30-year period.
nevoid basal cell carcinoma syndrome

Facial deformity secondary to multiple surgical procedures to remove basal cell carcinomas.
nevoid basal cell carcinoma syndrome
Clinical Features
- multiple whitish papules on the mucosa
- overlie the alveolar processes of neonates
- usually no more than 2 to 3 mm
- maxillary alveolus is more commonly involved
Histopathologic Features
- flattened epithelial lining
- parakeratotic luminal surface
- lumen contains keratinaceous debris
gingival cyst of the newborn

Multiple whitish papules on the alveolar ridge of a newborn infant.
gingival cyst of the newborn
What is the treatment and prognosis for gingival cyst of the newborn?
- no treatment indicated (rupture spontaneously)
- rarely seen after 3 months of age
Clinical Features
- soft tissue counterpart of lateral periodontal cyst
- predilection for mandibular canine/premolar area
- found in patients in the fifth and sixth decades
- almost invariably on facial gingiva or alveolar mucosa
- painless, domelike swellings less than 0.5 cm
- often bluish or blue-gray
Histopathologic Features
- thin, flattened epithelial lining
- focal plaques containing glycogen-rich clear cells
gingival cyst of the adult

Tense, fluid-filled swelling on the facial gingiva. Surgical excision revealed superficial “cupping out” of the alveolar bone.
gingival cyst of the adult

Low-power photomicrograph showing a thin-walled cyst in the gingival soft tissue, resembling lateral periodontal cyst.
gingival cyst of the adult

High-power photomicrograph showing a plaquelike thickening of the epithelial lining containing clear, glycogen-rich cells.
gingival cyst of the adult
What is the treatment and prognosis for gingival cyst of the adult?
- simple surgical excision
- prognosis is excellent

Clinical Features
- intrabony counterpart of gingival cyst of the adult
- often asymptomatic
- occur in fifth to seventh decades of life
- mandibular premolar-canine-lateral incisor area
- may have a polycystic appearance ("botryoid")
Radiographic Features
- well-circumscribed radiolucent area
- located laterally to roots of vital teeth
- less than 1.0 cm
Histopathologic Features
- thin, generally noninflamed, fibrous wall
- epithelial lining only one to three cells thick
- interspersed foci of glycogen-rich clear cells
- focal nodular thickenings composed of clear cells
lateral periodontal cyst

Radiolucent lesion located lateral to the roots of a vital mandibular canine and first premolar.
lateral periodontal cyst

A larger lesion located lateral to the roots of two vital teeth, causing root divergence.
lateral periodontal cyst

Gross specimen of a botryoid variant. Microscopically, this grapelike cluster revealed three separate cavities.
lateral periodontal cyst

- This photomicrograph shows a thin epithelial lining with focal nodular thickenings of clear cells.
- These thickenings often show a swirling appearance of the glycogen-rich clear cells.
lateral periodontal cyst
The calcifying odontogenic cyst is part of a spectrum of lesions characterized by odontogenic epithelium containing “ghost cells,” which then may undergo calcification. What are the three categories of calcifying odontogenic cysts?
- calcifying cystic odontogenic tumor
- dentinogenic ghost cell tumor
- ghost cell odontogenic carcinoma

Clinical Features
- equal frequency in the maxilla and mandible
- most found in incisor/canine areas (65%)
- most diagnosed in second to fourth decades of life
Radiographic Features
- unilocular, well-defined radiolucency
- radiopaque structures within the lesion
- most are between 2.0 and 4.0 cm
Histopathologic Features
- well-defined cystic lesion with a fibrous capsule
- lining of odontogenic epithelium, four to ten cells thick
- “ghost cells” within the epithelium (loss of nuclei)
calcifying odontogenic cyst

A well-circumscribed mixed radiolucent/radiopaque lesion in the right body of the mandible. Note root resorption of adjacent teeth.
calcifying odontogenic cyst

- Expansion of the posterior maxillary alveolus caused by a large pink lesion.
- Panoramic radiograph showing a large radiolucency with a small calcified structure is seen in the lower portion.
calcifying odontogenic cyst

A nodular mass of the mandibular facial gingiva. Radiography would reveal calcified structures within this lesion.
peripheral calcifying odontogenic cyst

The cyst lining shows ameloblastoma-like epithelial cells, with a columnar basal layer. Large eosinophilic ghost cells are present within the epithelial lining.
calcifying odontogenic cyst

Eosinophilic dentinoid material is present adjacent to a sheet of ghost cells.
calcifying odontogenic cyst
What is the treatment and prognosis for calcifying odontogenic cyst?
- simple enucleation
- recurrence is rare
Clinical Features
- most common in middle-aged adults (46 to 51 years)
- most occur in the mandible (75%)
- strong predilection for the anterior region
- asymptomatic (small) or painful expansion (large)
Radiographic Features
- unilocular or multilocular radiolucency
- well defined with a corticated rim
Histopathologic Features
- lined by squamous epithelium of varying thickness
- uneven hobnail and sometimes papillary surface
- mucin-producing goblet cells in the surface layer
- glandular, ductlike spaces within the epithelial lining
- mucicarmine-positive fluid within spaces
glandular odontogenic cyst

- Expansile lesion of the anterior mandible.
- Panoramic radiograph showing a large multilocular radiolucency.
glandular odontogenic cyst

The cyst is lined by stratified squamous epithelium that exhibits surface columnar cells with cilia. Numerous microcysts containing mucinous material are present.
glandular odontogenic cyst
What is the treatment and prognosis for glandular odontogenic cyst?
- enucleation or curettage
- propensity for recurrence (30%)
- decompression may promote shrinkage before surgery
Clinical Features
- develops on buccal of mandibular first or second molar
- occurs in children from 5 to 13 years of age
- slight-to-moderate tenderness
- swelling and foul-tasting discharge
- pocket formation on the buccal aspect
Radiographic Features
- well-circumscribed unilocular radiolucency
- involves buccal bifurcation and root area
- average size is 1.2 cm, but may be up to 2.5 cm
- root apices tipped toward lingual mandibular cortex
Histopathologic Features
- microscopic features are nonspecific
- lined by nonkeratinizing stratified squamous epithelium
- prominent chronic inflammatory cell infiltrate
buccal bifurcation cyst
What term is given to bifurcation cysts that occur distal or buccal to partially erupted mandibular third molars with a history of pericoronitis?
paradental cyst

Well-circumscribed unilocular radiolucency superimposed on the roots of the mandibular first permanent molar. Periodontal probing revealed pocket formation on the buccal aspect.
buccal bifurcation cyst

Axial computed tomography (CT) image showing a circumscribed radiolucency buccal to the roots of the mandibular first molar, which are tipping toward the lingual mandibular cortex.
buccal bifurcation cyst
What is the treatment and prognosis for buccal bifurcation cyst?
- enucleation (extraction is unnecessary)
- usually completely healed within 1 year
- some cases resolve without surgery
Clinical Features
- encountered most often in older patients (60 years)
- twice as common in men as in women
- pain and swelling are common complaints
Radiographic Features
- may mimic those of any odontogenic cyst
- radiolucent defect with irregular, ragged margins
Histopathologic Features
- well-differentiated or moderately well-differentiated
- transition from normal lining to squamous cell carcinoma
odontogenic carcinoma

Radiolucent lesion with irregular, ragged margins surrounding the crown of an impacted third molar in a 56-year-old woman. This was clinically considered to be a dentigerous cyst.
odontogenic carcinoma

Nineteen years previously, a large odontogenic keratocyst (OKC) with areas of epithelial dysplasia had been removed from the ascending ramus.
odontogenic carcinoma

High-power view of a dentigerous cyst from a 53-year-old man. The lining demonstrates full-thickness epithelial dysplasia.
odontogenic carcinoma

A dentigerous cyst from a 53-year-old man showing islands of invasive epithelial cells in the cyst wall.
odontogenic carcinoma
What is the treatment and prognosis for odontogenic carcinoma?
- varies from local block excision to radical resection
- possible radiation or adjunctive chemotherapy
- 2-year survival rate of 62%
- 5-year survival rate of 38%
What are the three classes of odontogenic tumors?
- tumors of odontogenic epithelium
- mixed odontogenic tumors
- tumors of odontogenic ectomesenchyme
What is the most common clinically significant odontogenic tumor?
ameloblastoma
What are the three different clinicoradiographic presentations of ameloblastoma?
- conventional solid or multicystic (80%)
- unicystic (18%)
- peripheral or extraosseous (2%)

Clinical Features
- equal prevalence in third to seventh decades
- most often occur in the mandible (80% to 85%)
- asymptomatic (small) or painless expansion (large)
Radiographic Features
- multilocular or unilocular radiolucent lesion
- “soap bubble” or “honeycombed” appearance
- resorption of the roots of adjacent teeth
- irregular, scalloped margins
Histopathologic Features
- islands of epithelium in a fibrous connective tissue stroma with ameloblast-like cells with reversed polarity (follicular type)
- cords or sheets of odontogenic epithelium with a loose, vascular stroma and ameloblast-like cells (plexiform type)
- extensive squamous metaplasia with keratin formation within epithelial islands (acanthomatous type)
- epithelial cells with abundant cytoplasm and eosinophilic granules (granular cell type)
- epithelial cells in a densely collagenized stroma with increased production of TGF-β (desmoplastic type)
- islands of uniform, hyperchromatic basaloid cells with peripheral palisading (basal cell type)
ameloblastoma

Large, painless expansile mass of the anterior mandible.
ameloblastoma

Prominent expansion of the lingual alveolus caused by a large, painless expansile mass of the mandibular symphysis.
ameloblastoma

Massive tumor of the anterior mandible.
ameloblastoma

Large multilocular lesion with “soap bubble” appearance involving the mandibular angle and ascending ramus.
ameloblastoma

Periapical films of a smaller multilocular lesion, showing a “honeycombed” appearance.
ameloblastoma

Destructive radiolucent lesion with root resorption of the associated posterior teeth.
ameloblastoma

Large mixed radiolucent and radiopaque lesion of the anterior and right body of the mandible. This type has a predilection for anterior region, with equal distribution between mandible and maxilla.
desmoplastic ameloblastoma

Multiple islands of odontogenic epithelium demonstrating peripheral columnar differentiation with reverse polarization. The central zones resemble stellate reticulum and exhibit foci of cystic degeneration.
ameloblastoma, follicular pattern

This high-power photomicrograph highlights a single layer of tall columnar ameloblast-like cells exhibiting reverse polarization, surrounding a central core of loosely arranged angular cells resembling the stellate reticulum.
ameloblastoma, follicular pattern

Tumor demonstrating anastomosing cords of odontogenic epithelium.
ameloblastoma, plexiform pattern

Islands of ameloblastoma demonstrating central squamous differentiation.
ameloblastoma, acanthomatous pattern

Tumor island exhibiting central cells with prominent granular cytoplasm.
ameloblastoma, granular pattern

Thin cords of ameloblastic epithelium within a dense fibrous connective tissue stroma.
ameloblastoma, desmoplastic pattern

Islands of hyperchromatic basaloid tumor cells with peripheral palisading.
ameloblastoma, basal cell pattern

- Gross photograph of a mandibular resection specimen.
- The radiograph of the specimen shows a large radiolucent defect associated with an inferiorly displaced third molar.
ameloblastoma
What is the treatment and prognosis for conventional solid or multicystic intraosseous ameloblastoma?
- ranges from enucleation and curettage to en bloc resection
- recurrence rates of 50% to 90% have been reported
- marginal resection is the most widely used treatment,
Clinical Features
- most often in younger patients (second decade of life)
- most often in mandible (90%), especially posterior
- asymptomatic (small) or painless swelling (large)
Radiographic Features
- circumscribed radiolucency
- surrounds crown of unerupted mandibular third molar
Histopathologic Features
- fibrous cyst wall with lining of ameloblastic epithelium confined to the luminal surface (luminal type)
- one or more nodules project from the cystic lining into the lumen of the cyst (intraluminal type)
- fibrous wall of the cyst is infiltrated by follicular or plexiform ameloblastoma (mural type)
ameloblastoma, unicystic

A large radiolucency in the posterior mandible associated with the crown of the developing mandibular third molar.
unicystic ameloblastoma

Coronal computed tomography (CT) image that shows a large cystic lesion with an intraluminal mass arising from the cyst wall.
unicystic ameloblastoma

The cyst is lined by ameloblastic epithelium showing a hyperchromatic, polarized basal layer. The overlying epithelial cells are loosely cohesive and resemble stellate reticulum.
unicystic ameloblastoma, luminal type

Photomicrograph of an intraluminal mass arising from the ameloblastic epithelium of the cyst wall. The inset shows the intraluminal mass at higher magnification.
unicystic ameloblastoma, intraluminal type

The epithelial lining of the cystic component can be seen on the left edge of the photomicrograph. Islands of follicular ameloblastoma are infiltrating into the fibrous connective tissue wall on the right.
unicystic ameloblastoma, mural type
What is the treatment and prognosis for unicystic ameloblastoma?
- enucleation and curettage
- recurrence rates of 10% to 20%
Clinical Features
- painless, nonulcerated sessile or pedunculated lesion
- common on posterior gingival or alveolar mucosa
- often smaller than 1.5 cm
- seen in middle-aged persons (52 years)
Histopathologic Features
- islands of ameloblastic epithelium in lamina propria
- may merge with basal layer of surface epithelium
peripheral ameloblastoma

A painless, nonulcerated sessile mass arising from the alveolar mucosa which appears similar to a fibroma or pyogenic granuloma.
peripheral ameloblastoma

Interconnecting cords of ameloblastic epithelium filling the lamina propria.
peripheral ameloblastoma
What is the treatment and prognosis for peripheral ameloblastoma?
- local surgical excision
- recurrence rate of 15% to 20%
- malignant change possible, but rare
Clinical Features
- tend to develop later in life (sixth decade)
- affects men twice as often as women
- aggressive clinical course
Radiographic Features
- ill-defined margins
- rapid cortical destruction
Histopathologic Features
- microscopic pattern similar to ameloblastoma
- increased nuclear-to-cytoplasmic ratio
- nuclear hyperchromatism
- presence of mitoses
- necrosis or dystrophic calcification may be present
ameloblastic carcinoma

- Rapidly growing tumor showing prominent labial expansion of the mandible in the incisor and premolar area.
- The panoramic radiograph shows irregular destruction of the mandible.
ameloblastic carcinoma

Ameloblastic epithelium demonstrating hyperchromatism, pleomorphism, and numerous mitotic figures.
ameloblastic carcinoma
What is the treatment and prognosis for ameloblastic carcinoma?
- poor prognosis
- uniformly aggressive clinical course
- 50% mortality with long-term follow-up
Clinical Features
- most often diagnosed in patients older than age 50
- most often develops in the mandible (80%)
- patients complain of pain or lower lip paresthesia
- aggressive clinical course
Radiographic Features
- unilocular or multilocular radiolucencies
- ill-defined or irregular margins
Histopathologic Features
- nests of epithelial cells with clear cytoplasm
- amixed eosinophilic polygonal epithelial cells
- occasional palisading of peripheral clear cells
clear cell odontogenic carcinoma

A unilocular radiolucent defect at the apex of the mandibular first molar. This patient complained of pain and lower lip paresthesia.
clear cell odontogenic carcinoma

Hyperchromatic epithelial nests including clusters of cells with abundant clear cytoplasm.
clear cell odontogenic carcinoma

Tumor island demonstrating cells with a clear cytoplasm. Note the peripheral columnar differentiation.
clear cell odontogenic carcinoma
What is the treatment and prognosis for clear cell odontogenic carcinoma?
- significant tendency to recur
- most require fairly radical surgery
- can metastasize to lymph nodes and lungs

Clinical Features
- largely limited to younger patients (10 to 19 years)
- striking predilection for anterior portions of the jaws
- found twice as often in the maxilla as in the mandible
- affect females about twice as often as males
- seldom exceed 3 cm and frequently asymptomatic
Radiographic Features
- circumscribed, unilocular radiolucency
- involves crown of unerupted tooth (often canine)
- sometimes extends apically along the root
- can also be located between roots of erupted teeth
- often contains fine "snowflake" calcifications
Histopathologic Features
- well-defined lesion surrounded by a thick, fibrous capsule
- spindle-shaped epithelial cells in sheets, strands, or whorls
- tubular or ductlike structures wihtout glandular elements
- occasional scattered foci of calcification
adenomatoid odontogenic tumor

Radiolucent lesion involving an unerupted mandibular first premolar. In contrast to the usual dentigerous cyst, the radiolucency extends almost to the apex of the tooth.
adenomatoid odontogenic tumor

A small radiolucency is present between the roots of the lateral incisor and canine. These lesions may occasionally contain fine "snowflake" calcifications.
adenomatoid odontogenic tumor

Well-defined pericoronal radiolucency enveloping the maxillary right lateral incisor in a 14-year-old male. Note the subtle snowflake-like calcifications within the lesion.
adenomatoid odontogenic tumor

A well-circumscribed cystlike mass can be seen enveloping the crown of a maxillary cuspid. Note the intraluminal vegetations, which represent nodular tumor growth.
adenomatoid odontogenic tumor

- Low-power view demonstrating a thick capsule surrounding the tumor.
- Higher magnification showing the ductlike epithelial structures. The nuclei of the columnar cells are polarized away from the central spaces.
adenomatoid odontogenic tumor
What is the treatment and prognosis for adenomatoid odontogenic tumor?
- enucleates easily from bone
- recurrence after enucleation seldom
- completely benign

Clinical Features
- encountered in patients between 30 and 50 years
- two-thirds are found in the mandible (posterior areas)
- painless, slow-growing swelling
Radiographic Features
- unilocular or multilocular radiolucent defect
- scalloped, well-defined margins
- frequently associated with an impacted tooth
- traditionally described “driven-snow” calcifications
Histopathologic Features
- polyhedral epithelial cells in a fibrous stroma
- distinct cellular outlines and intercellular bridges
- variable and occasionally giant nuclei
- hyalinized (amyloid-like) extracellular material
- concentric calcifications ("Liesegang rings")
- apple-green birefringence after Congo red staining
calcifying epithelial odontogenic tumor ("Pindborg tumor")

Honeycombed multilocular radiolucency containing fine calcifications.
calcifying epithelial odontogenic tumor

Prominent calcification around the crown of an impacted second molar that is involved in the tumor.
calcifying epithelial odontogenic tumor

- Sheets of epithelial tumor cells that surround pools of amorphous, eosinophilic amyloid with focal calcification.
- Higher-power view showing polyhedral cells with eosinophilic cytoplasm and intercellular bridging. Adjacent amyloid deposits can be seen.
calcifying epithelial odontogenic tumor

Multiple concentric Liesegang ring calcifications.
calcifying epithelial odontogenic tumor

With Congo red staining, pools of amyloid exhibit an apple-green birefringence when viewed with polarized light.
calcifying epithelial odontogenic tumor
What is the treatment and prognosis for calcifying epithelial odontogenic tumor?
- conservative local resection
- recurrence rate of 15%
- rare cases of malignancy
Clinical Features
- found in patients from 8 to 74 years (average, 38)
- painless or mildly painful gingival swelling
- mobility of associated teeth
Radiographic Features
- triangular radiolucent defect lateral to roots of teeth
- ill defined or well-defined, corticated margin
- seldom exceed 1.5 cm
Histopathologic Features
- islands of bland-appearing squamous epithelium
- mature fibrous connective tissue stroma
- vacuolization and individual cell keratinization
- small microcysts are sometimes observed
squamous odontogenic tumor

A triangular radiolucent defect extending along the roots of the lateral incisor and first premolar teeth.
squamous odontogenic tumor

- Low-power photomicrograph showing islands of bland-appearing squamous epithelium in a fibrous stroma.
- Higher-power photomicrograph showing bland appearance of the epithelium with microcyst formation.
squamous odontogenic tumor
What is the treatment and prognosis for squamous odontogenic tumor?
- conservative local excision or curettage
- recurrence rare after local excision
- maxillary tumors may be somewhat more aggressive
- malignant transformation is possible

Clinical Features
- occur in younger patients (first two decades)
- more common in males than in females
- asymptomatic (small) or swelling (large)
- posterior mandible is the most common site (70%)
- solid, soft tissue mass with a smooth outer surface
Radiographic Features
- unilocular or multilocular radiolucent lesion
- margins tend to be well-defined and corticated
- often associated with an unerupted tooth (75%)
Histopathologic Features
- cell-rich mesenchymal tissue
- long, narrow cords of odontogenic epithelium
- mesenchymal portion of plump stellate and ovoid cells
ameloblastic fibroma

Multilocular radiolucent defect with well defined, corticated margins associated with an unerupted second molar.
ameloblastic fibroma

- Long, narrow cords of odontogenic epithelium supported by richly cellular, primitive connective tissue.
- Basophilic epithelial islands with peripheral nuclear palisading.
ameloblastic fibroma
What is the treatment and prognosis for ameloblastic fibroma?
- conservative initial therapy
- high recurrance rate (up to 43.5%)
- aggressive surgical excision for recurrent lesions
- transformation accounts for 35% of ameloblastic fibrosarcoma

Clinical Features
- usually seen in children (average, 10 years)
- most frequent in the posterior mandible
- males affected more often than females (3 : 2)
- asymptomatic (small) or painless swelling (large)
Radiographic Features
- well-circumscribed radiolucent defect
- unilocular or (infrequently) multilocular
- flecks or masses of calcified material
- often associated with an unerupted tooth
Histopathologic Features
- microscopically identical to ameloblastic fibroma
- narrow cords and small islands of odontogenic epithelium
- loose connective tissue resembling the dental papilla
- calcified elements consisting of enamel and dentin matrix
ameloblastic fibro-odontoma

Radiolucent defect in the ramus containing small calcifications having the radiodensity of tooth structure.
ameloblastic fibro-odontoma

Unilocular radiolucent defect displacing the developing mandibular third molar posteriorly. Flecks of mineralized material are present in the radiolucent defect.
ameloblastic fibro-odontoma

- The soft tissue component of the tumor is indistinguishable from an ameloblastic fibroma.
- Formation of disorganized tooth structure can be seen.
ameloblastic fibro-odontoma
What is the treatment and prognosis for ameloblastic fibro-odontoma?
- conservative curettage
- prognosis is excellent
- low recurrence rate (7%)
Clinical Features
- rare malignant counterpart of ameloblastic fibroma
- occurs 1.5 times as often in males as in females
- tends to occur in younger patients (27.5 years)
- occurs most often in the mandible (80%)
Radiographic Features
- ill-defined destructive radiolucent lesion
- locally aggressive and infiltrates adjacent bone
Histopathologic Features
- benign-appearing epithelial component
- highly cellular mesenchymal portion
- hyperchromatic and bizarre pleomorphic cells
- mitoses are usually prominent
ameloblastic fibrosarcoma

- A 21-year-old woman complained of facial asymmetry and recent increase in size of a mandibular mass that had been present for some years.
- Radiograph of the same patient. Note the lytic destruction of the posterior mandible.
ameloblastic fibrosarcoma

The cellular mesenchymal tissue shows hyperchromatism and atypical cells. A small island of benign-appearing ameloblastic epithelium is present.
ameloblastic fibrosarcoma
What is the treatment and prognosis for ameloblastic fibrosarcoma?
- radical surgical excision
- estimated 20% of patients succumb to their tumor
Clinical Features
- occurs more often in younger patients
- pain, delayed eruption of teeth, expansion of bone
- tends to occur in younger patients (27.5 years)
- occurs most often in the mandible (80%)
Radiographic Features
- radiolucent, destructive lesion
- contains calcified structures
Histopathologic Features
- epithelial features of an ameloblastoma
- dental tissue with appearance of an odontoma
odontoameloblastoma
What is the most common type of odontogenic tumor?
odontoma
Clinical Features
- most detected during first two decades (14 years)
- completely asymptomatic and relatively small
- more frequent in the maxilla than the mandible
Radiographic Features
- collection of toothlike structures (compound type)
- conglomerate mass of enamel and dentin (complex type)
- narrow radiolucent rim
- frequently associated with an unerupted tooth
Histopathologic Features
- multiple structures resembling small, single-rooted teeth in a loose fibrous matrix (compound type)
- largely a mature tubular dentin enclosing clefts that contain mature enamel (complex type)
odontoma

A small cluster of toothlike structures is preventing the eruption of the maxillary canine.
compound odontoma

Multiple toothlets preventing the eruption of the mandibular cuspid.
compound odontoma

A calcified mass with the radiodensity of tooth structure, overlying the crown of the mandibular right second molar.
complex odontoma

Surgical specimen consisting of more than 20 malformed toothlike structures.
compound odontoma

This decalcified section shows a disorganized mass of dentin intermixed with small pools of enamel matrix.
complex odontoma
What is the treatment and prognosis for complex odontoma?
- simple local excision
- prognosis is excellent

Clinical Features
- occur between 4 to 80 years (mean, 40 years)
- strong female predilection (almost 2 : 1)
- maxillary lesions located anterior to first molar
- mandibular lesions located posterior to first molar
- one-third associated with an unerupted tooth
- asymptomatic (small) or bony expansion (large)
- defect or groove in overlying palatal mucosa
Radiographic Features
- unilocular or multilocular radiolucent lesions
- well-defined, corticated border
- associated with periradicular area of erupted teeth
- root resorption of associated teeth is common
Histopathologic Features
- stellate fibroblasts in a whorled pattern
- fine collagen fibrils and abundant ground substance
- cellular fibrous connective tissue with collagen fibers
- odontogenic epithelium in long strands or isolated nests
odontogenic fibroma

- Clinical image showing a groove or defect in the palatal mucosa, a feature described with maxillary lesions.
- Radiograph of this patient, depicting a multilocular radiolucency of the anterior maxilla.
odontogenic fibroma
Scattered stellate fibroblasts within a collagenous background. No epithelial rests were found on multiple sections from this tumor.
odontogenic fibroma, simple type

A cellular fibroblastic lesion containing narrow cords of odontogenic epithelium and collagen fibers arranged in interlacing bundles.
odontogenic fibroma, WHO type

- Unilocular radiolucency between the left mandibular bicuspids.
- Microscopic examination reveals two distinct patterns. Cords of odontogenic epithelium within a fibrous background on the left, with features of giant cell granuloma on the right.
odontogenic fibroma associated with a giant cell granuloma
What is the treatment and prognosis for odontogenic fibroma?
- enucleation and vigorous curettage
- recurrence is rare
- prognosis is very good
Clinical Features
- soft tissue counterpart of odontogenic fibroma
- firm, slow-growing, sessile gingival mass
- covered by normal-appearing mucosa
- most often on mandibular facial gingiva
- most are between 0.5 and 1.5 cm
Radiographic Features
- demonstrate a soft tissue mass
- some show areas of calcification
- occasional “cupped out” appearance
Histopathologic Features
- similar to central odontogenic fibroma (WHO type)
- interwoven fascicles of cellular fibrous connective tissue
- areas of less cellular, myxoid connective tissue
- scattered islands or strands of odontogenic epithelium
peripheral odontogenic fibroma

This sessile gingival mass cannot be clinically distinguished from the common peripheral ossifying fibroma.
peripheral odontogenic fibroma
What is the treatment and prognosis for peripheral odontogenic fibroma?
- local surgical excision
- prognosis is good
- recurrence is possible
Clinical Features
- only ever diagnosed in adults (50% over 40 years)
- most cases have developed in women (70%)
- occurs in mandiblular premolar/molar region
- asymptomatic or painless expansion of bone
Radiographic Features
- well-demarcated radiolucency
- unilocular or multilocular
- occasionally shows small calcifications
Histopathologic Features
- large eosinophilic granular cells
- narrow cords or small islands of odontogenic epithelium
- cementum-like or dystrophic calcifications
granular cell odontogenic tumor

Well-demarcated unilocular radiolucent lesion involving the apical area of endodontically treated maxillary teeth. These lesions occasionally show small calcifications.
granular cell odontogenic tumor

Sheet of large granular mesenchymal cells with small nests of odontogenic epithelium.
granular cell odontogenic tumor
What is the treatment and prognosis for granular cell odontogenic tumor?
- appears to be completely benign
- responds well to curettage
- one reported case of recurrence
- one reported case of malignancy

Clinical Features
- predominantly found in young adults (25 to 30 years)
- mandible is involved more commonly than maxilla
- rapid clinical growth in some cases
Radiographic Features
- unilocular or multilocular radiolucency
- may displace or cause resorption of teeth
- irregular or scalloped margins
- may contain wispy trabeculae at right angles
- may show a “soap bubble” radiolucent pattern
Histopathologic Features
- haphazard stellate, spindle-shaped, and round cells
- abundant, gelatinous, loose myxoid stroma
- ground substance composed of glycosaminoglycans
odontogenic myxoma

Unilocular radiolucency between the right mandibular lateral incisor and cuspid. These lesions may show wispy trabeculae of residual bone in a “stepladder” pattern.
odontogenic myxoma

Radiolucent lesion of anterior maxilla showing fine residual bone trabeculae arranged at right angles to one another (“stepladder” pattern).
odontogenic myxoma

Multilocular expansile radiolucency of the posterior mandible with wispy trabeculae of residual bone.
odontogenic myxoma

Gross specimen of a mandibular jaw lesion, demonstrating a white gelatinous mass.
odontogenic myxoma

A loose, myxomatous tumor can be seen filling the marrow spaces between the bony trabeculae. The inset shows stellate-shaped cells and fine collagen fibrils.
odontogenic myxoma
What is the treatment and prognosis for odontogenic myxoma?
- curettage or more extensive resection
- careful periodic reevaluation for at least 5 years
- recurrence rate of 25%